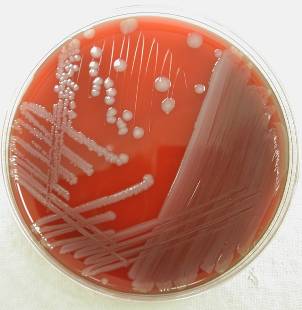

Salmonella Reduction Programmes
Ideas to reduce the prevalence of Salmonella on pig and poultry farms
Salmonella - the bacteria general
Salmonella control programme basics
Salmonella control programme report
Issues with Salmonella on the farm
Salmonella colonies growing in the lab on agar